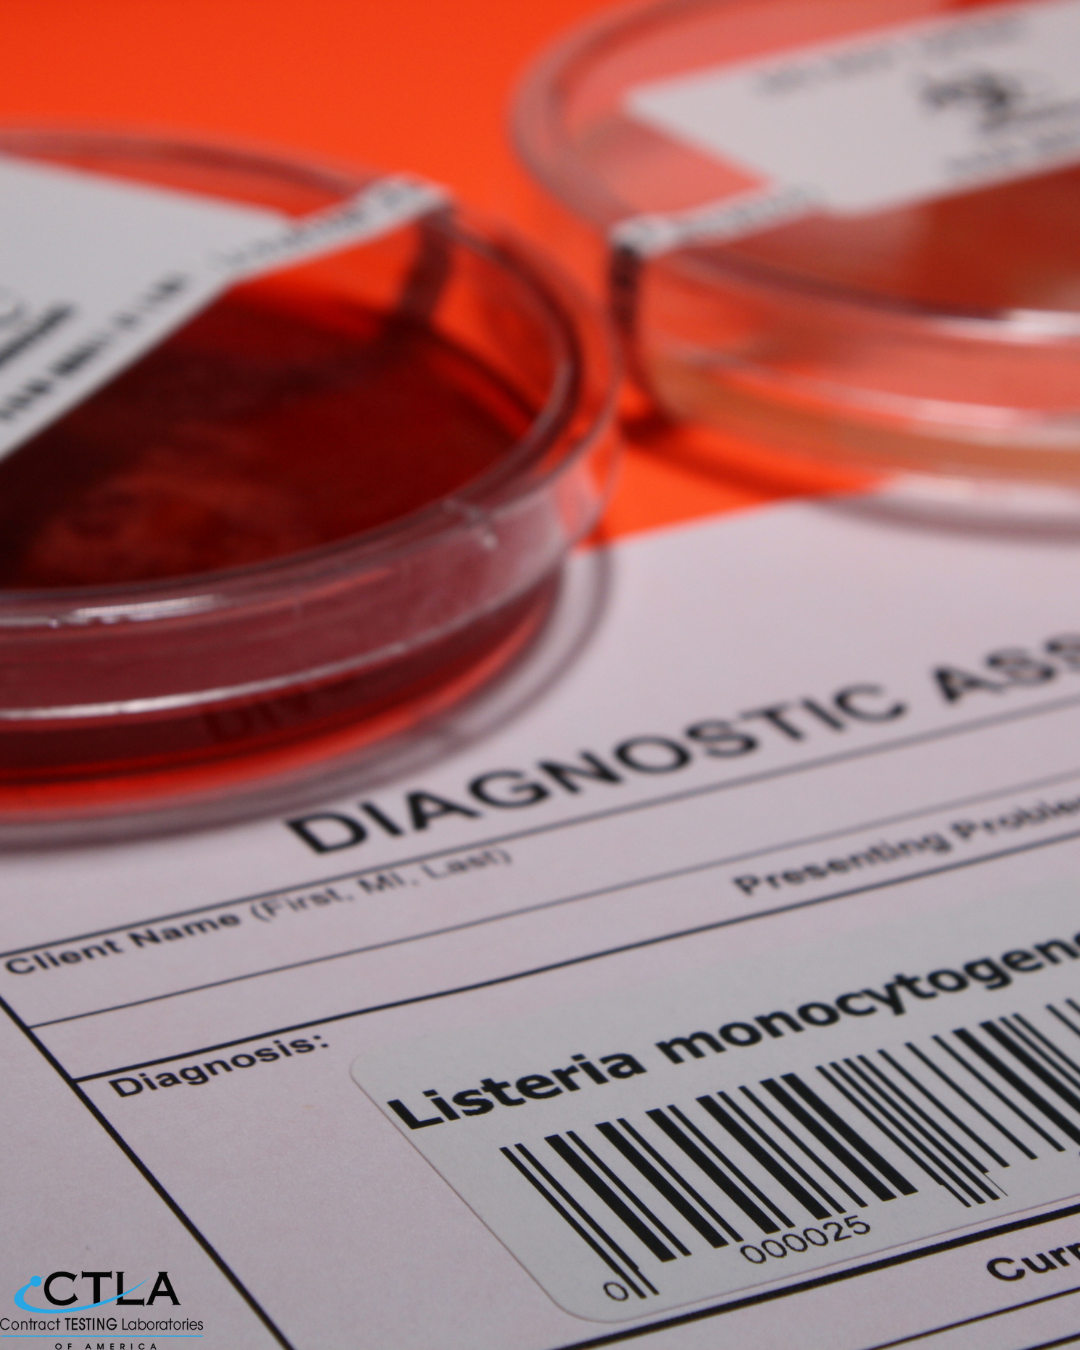
Listeria-The latest threat to American health

Welcome to Contract Testing Laboratories of America (CTLA)
CTLA stands as a leading full-service laboratory specializing in comprehensive testing for dietary supplements, food, and cosmetics. Our extensive range of services covers vital aspects such as microbiology, identity, metals, vitamins, and more—all conducted in strict compliance with the rigorous requirements set forth by the United States Food and Drug Administration (FDA). As a FDA-recognize facility, we not only prioritize regulatory standards but also communicate a commitment to the highest-quality safety benchmarks, both to product brands and consumers alike.
Our dedication goes beyond mere compliance. CTLA is your proactive partner in keeping your products and manufacturing processes safe and in adherence to FDA regulations and third-party certifications. Through our meticulous testing services, we provide an early detection system for potential issues during the manufacturing stages, ensuring that your products meet the stringent public health standards. This proactive approach not only safeguards against forced recalls but also contributes to the financial and social well-being of your company, fostering trust and long-term success in the market.
Our Services
Explore our comprehensive suite of services, from microbiology to metals, meticulously designed to meet FDA standards and exceed your expectations. With CTLA, elevate your commitment to excellence and empower your brand with confidence in every test

Supplement Testing
CTLA’s services meet all the requirements of the United States (US) Food and Drug Administration (FDA) for dietary supplements and ingredients following the 1994 Dietary Supplement Health and Education Act (DSHEA). CTLA is a third-party testing facility which evaluates the safety and labeling of dietary supplement health products as required by US law.

Food Testing Services
CTLA's testing services will provide peace of mind that your foods are free from harmful microorganisms and heavy metal contamination. Food can easily be contaminated with microorganisms and/or heavy metals from soil, air, or water sources. We also do Nutritional Panel testing to verify that what is on the label is in our sample.

Cosmetic Testing
CTLA provides every cosmetics testing required by the Food, Drug, and Cosmetic Act (FDCA) as regulated by the US Food and Drug Administration (FDA). According to the FDCA, all companies manufacturing or marketing cosmetics products are legally required to test for the safety and proper labeling of each cosmetic product.
Why choose us?
Contact
Articles from our blog
Listeria-The latest threat to American health
Ensure food safety and compliance during recalls with CTLA's advanced Listeria testing services. At Contract Testing Laboratories of America (CTLA), our microbiology experts use state-of-the-art me...
Read more
As the industry evolves, these labs are now embracing advanced technologies like polymerase chain reaction (PCR) testing, setting new benchmarks for quality assurance.
Read more
CTLA stands out as the premier choice for your testing needs
Contract Testing Laboratories of America (CTLA) stands out as the premier choice for companies seeking comprehensive and reliable testing services for dietary supplements, food, and cosmetics. As a...
Read more





